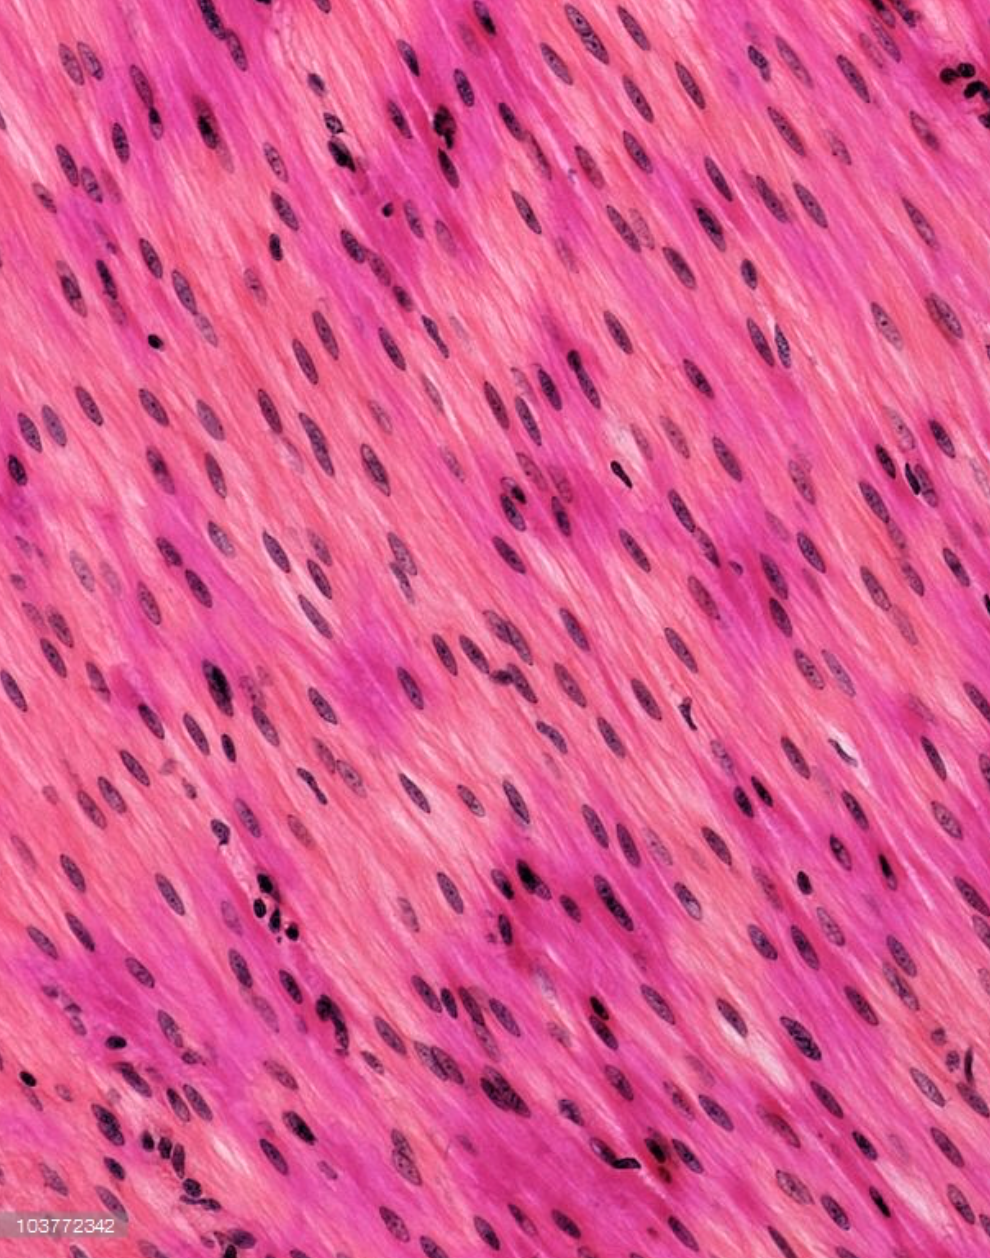

Hyaline cartilage

Elastic cartilage

Fibrocartilage

Skeletal Muscle

Cardiac muscle
Smooth Muscle

simple squamous epithelium (in lungs)

pseudostratified ciliated columnar epithelium
Simple Squamous Epithelium (description)
single layer of irregular and flat cells
Simple Cuboidal Epithelium (description)
single layer of cells that are as tall as they are wide
Simple Columnar Epithelium (description)
Single layer of cells that are taller than they are wide
Pseuodostratified Ciliated Columnar Epithelium
single layer that looks like multiple layers that is taller than it is wide and has cilia on the top
Stratified Squamous Epithelium (description)
multiple layers that are wider than tall
Transitional Epithelium (description)
multiple layers that when relaxed are rounded and when contracted are squamous
Adipose Connective Tissue (description)
fatty looking cells
Aereolar Connective Tissue (description)
Random arrangement of collagen, elastin, and reticuar fibers
Dense Regular Connective Tissue (description)
Parallel arrangment of collagen fibers
Dense Irregular Connective Tissue (description)
random arrangment of collagen fibers
Elastic Connective Tissue (description)
Elastic fibers present
Reticular connective tissue (description)
Random arrangement of reticular fibers
Hyaline Cartilage (description)
Gel-like ground substance with collagen and elastic fibers that are present, but not seen
Elastic Cartilage (description)
Gel-like ground substance with elastin and collagen present
Fibrocartilage (description)
Parallel arrangement of fibers with a gel-like ground substance and collagen and some elastin
Cardiac Muscle (description)
Striated, mononucleiated, involuntary contractions, looks like tree branches


